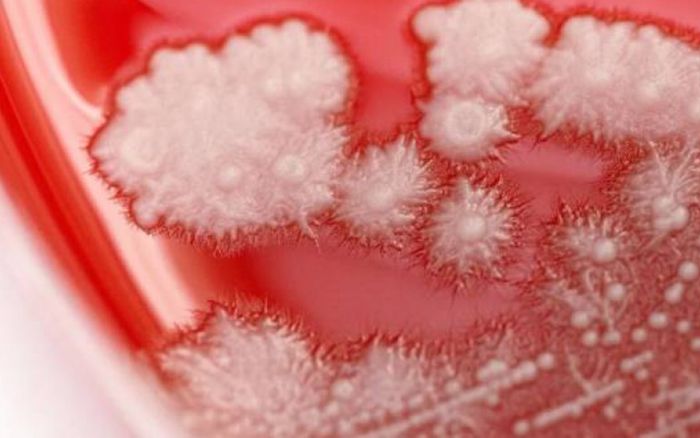
Tự ý dùng kháng sinh do bị đau họng, người đàn ông 36 tuổi gặp tình trạng khiến ai cũng kinh hãi

Tự ý dùng kháng sinh do bị đau họng, người đàn ông 36 tuổi gặp tình trạng khiến ai cũng kinh hãi
Sự việc của người đàn ông thu hút sự quan tâm mạnh mẽ.
Tìm theo từ khóa
Sự việc của người đàn ông thu hút sự quan tâm mạnh mẽ.

Tắm đêm bằng nước lạnh, người đàn ông 30 tuổi, bất ngờ bị ù tai trái, nghe kém, đau nhức, hai ngày sau mất hoàn toàn thính lực.

Có bốn người lạ mặt đứng trước cổng trường tiểu học Lý Tự Trọng phát thứ này cho học sinh rồi nhanh chóng rời đi. 31 học sinh tiểu học sau đó phải nhập viện khẩn.

Nhiều người bị ngộ độc món ăn tưởng như vô hại, các chuyên gia đầu ngành của BV Chợ Rẫy được cử mang thuốc giải hiếm đến Quảng Nam hỗ trợ cứu người.

Nghe mọi người mách sau sinh nuốt mật lợn có thể chữa đau bụng, tốt đường tiêu hóa nên gia đình đã đi xin một túi mật lợn còn tươi về để cho chị nuốt.

Gia đình thấy bé 2 tháng tuổi lịm dần đi nên vội đưa đến Bệnh viện Sản Nhi Phú Thọ để cấp cứu. Trước đó, bé bị sốt cao, kèm triệu chứng ho, khò khè.

Cháu bé vừa bị tử vong là một nam sinh lớp 1 Trường Ischool Nha Trang, có tên nước ngoài (ba là người nước ngoài, mẹ người Việt Nam).

Vừa qua, Bệnh viện Sản Nhi tỉnh Phú Thọ liên tục ghi nhận các trường hợp trẻ bị ong đốt đến khám và điều trị, trong đó cá biệt có trường hợp trẻ bị sốc phản vệ, suy đa tạng rất nguy hiểm.

Ngưng tim 20 phút, nam bệnh nhân sau đó được các bác sĩ cứu sống ngoạn mục.

Ông Nguyễn Hồng Tâm - Phó Giám đốc Trung tâm Kiểm soát bệnh tật TP.HCM (HCDC), cho rằng ca mắc đậu mùa khỉ đầu tiên và ca mắc đậu mùa khỉ thứ hai của Việt Nam có thể lây qua nhau hoặc lây qua từ người khác.

“Khi được trở lại trường đi học, em như bắt đầu một cuộc sống mới. Một cuộc sống thứ 2. Em trở về từ cõi chết nên cảm thấy yêu quý cuộc sống này lắm. Cuộc sống này thật tuyệt vời”, Kiệt híp mắt cười nói.

Theo chuyên gia, bệnh đậu mùa khỉ có khả năng lây lan nhưng nó khó lây hơn những bệnh truyền nhiễm khác.

Bệnh đậu mùa khỉ là bệnh lây truyền từ động vật sang người, việc lây truyền từ người sang người khi tiếp xúc trực tiếp hoặc tiếp xúc gần, lây qua vết thương hở, dịch cơ thể, giọt bắn lớn của đường hô hấp và qua tiếp xúc với các vật dụng, đồ dùng bị nhiễm mầm bệnh.

Việt Nam đã ghi nhận ca mắc đậu mùa khỉ đầu tiên tại TP Hồ Chí Minh thông qua giám sát dịch tễ. Để chủ động phòng chống dịch bệnh đậu mùa khỉ ở nước ta, Bộ Y tế khuyến cáo người dân chủ động thực hiện 6 biện pháp phòng bệnh.

Nữ bệnh nhân nhập viện trong tình trạng gầy yếu (32kg), cơ thể nhợt nhạt, yếu ớt, đi ngoài trên 20 lần/ngày, phân vàng lỏng, có khi phân đen.

Theo Bộ Y tế, nước ta đối mặt với nguy cơ tiềm ẩn dịch đậu mùa khỉ xâm nhập trong cộng đồng và các cơ sở khám chữa bệnh.

Kể từ khi xuất hiện triệu chứng, hai người đàn ông tại Pháp không để chó cưng tiếp xúc với người và vật nuôi khác nhưng chú chó đã ngủ cùng họ.

Trước khi nhập viện 7 giờ, bệnh nhân xuất hiện tình trạng yếu nửa người trái, ở nhà nghỉ ngơi không đỡ, được gia đình đưa đến cơ sở y tế gần nhất sau đó được chuyển lên Bệnh viện đa khoa tỉnh Phú Thọ cấp cứu và điều trị.

Những ngày gần đây, số lượng bệnh nhân mắc cúm A có dấu hiệu gia tăng đột biến bao gồm cả trẻ em với tình trạng nặng, có tổn thương phổi, phải nhập viện điều trị. Dưới đây là một số dấu hiệu nhận biết và cách chăm sóc, phòng bệnh.

Các bác sĩ khoa Phụ sản, Bệnh viện Đa khoa tỉnh Quảng Ninh đã phẫu thuật bóc tách, bảo tồn tử cung thành công cho bệnh nhân nữ, 30 tuổi.